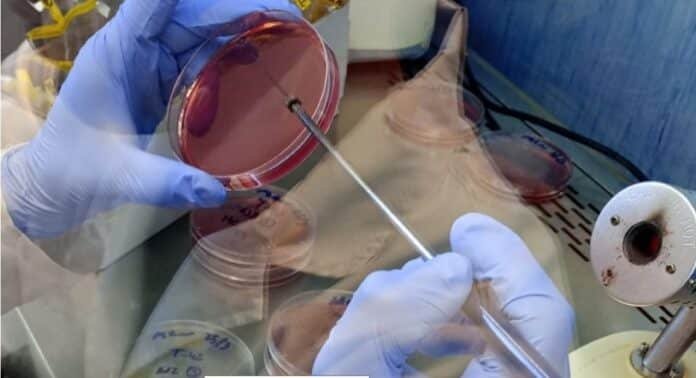
laboratorio-inta-analisis-salmonella-avicultura-ruralnet Técnico realizando análisis microbiológico en laboratorio del INTA con placas de cultivo para detección de Salmonella en producción avícola

Concepción del Uruguay entra a la red nacional y mejora tiempos de diagnóstico en una enfermedad crítica para el sector
La sanidad avícola suma una herramienta estratégica:
el laboratorio del INTA Concepción del Uruguay ya tiene validez oficial para detectar Salmonella y se integra a la red nacional del SENASA.
El impacto es directo en el negocio: diagnósticos más rápidos, confiables y con respaldo oficial para la producción avícola.
El dato clave: análisis con validez oficial
La incorporación a la Red Nacional de Laboratorios marca un cambio concreto.
Desde ahora, el laboratorio puede:
- Emitir resultados reconocidos oficialmente
- Trabajar bajo estándares unificados en todo el país
- Acelerar la respuesta ante problemas sanitarios
En esta primera etapa, el foco está en Salmonella spp., una de las enfermedades más sensibles para la cadena.
Por qué importa la Salmonella
No es un tema menor.
La presencia de Salmonella impacta en:
- Sanidad de las aves
- Calidad del producto
- Acceso a mercados
- Costos productivos
Por eso, la velocidad y precisión del diagnóstico son clave.
Te puede interesar
Pronóstico de lluvias hasta el 6 de abril
Retenciones cero y desregulación: el nuevo jefe de Agricultura en el Senado fija agenda para el campo
Dólar atrasado y campos baratos: prevén subas fuertes y piden un tipo de cambio de $1550
Pick-ups: hasta 75% menos gasto o máxima autonomía, qué conviene hoy entre híbrida y diésel
La hacienda se afirma y arranca la retención: el negocio ganadero apunta a un nuevo salto
Se agrava un problema clave del agro: máquinas cada vez más grandes y rutas que no alcanzan
El sueldo del peón rural pega un salto en 2026 y supera el millón de pesos
Más rapidez, menos riesgo
Con esta habilitación, el sector gana en eficiencia:
- Menor tiempo de análisis
- Respuestas más confiables
- Mejor toma de decisiones sanitarias
Esto permite actuar antes y reducir pérdidas en los sistemas productivos.
Un paso que llevó más de un año
La incorporación no fue inmediata.
El proceso incluyó:
- Adecuación de protocolos
- Implementación de sistemas de calidad
- Capacitación técnica del equipo
El resultado es un laboratorio alineado con normas nacionales e internacionales.
Qué cambia para el productor
El beneficio es concreto:
- Mayor respaldo en análisis sanitarios
- Mejor control de enfermedades
- Más previsibilidad productiva
En una cadena donde los márgenes dependen de la sanidad, esto suma competitividad.
Lo que viene: ampliar capacidades
El trabajo no termina acá.
El equipo ya avanza en:
- Nuevos tipos de análisis
- Mayor alcance diagnóstico
- Más servicios para el sector
La meta es clara: convertirse en un nodo clave para la sanidad avícola regional.
Un refuerzo para toda la cadena
La integración a la RedLab no solo mejora al laboratorio.
Fortalece:
- El sistema sanitario nacional
- La trazabilidad de los análisis
- La confianza en los resultados
En un sector cada vez más exigente, la sanidad se vuelve un factor decisivo de competitividad.